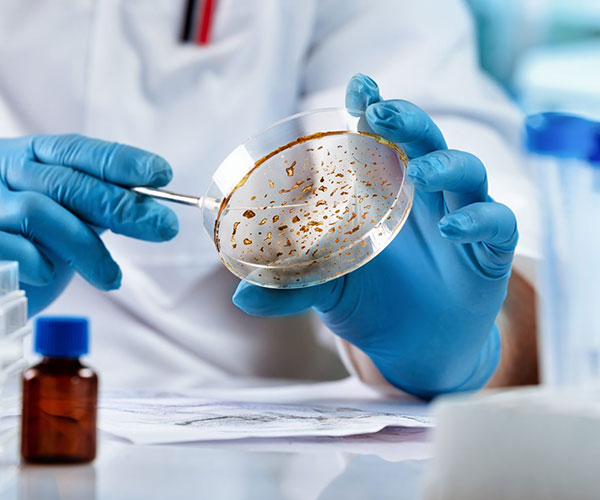

- Admin
- 10 March, 2025
- 3 Comments
- UI/UX Strategy
Reiterate the importance of embracing emerging trends and technological advancements in medical laboratories to provide state-of-the-art patient care. Emphasize the need for ongoing learning and adaptation to meet the evolving demands of healthcare. The future holds immense potential for medical laboratories to advance diagnostics, treatment, and research, ultimately improving patient outcomes and transforming the field of healthcare.
Introduce the topic of the future of medical laboratories and the impact of emerging trends and technological advancements. Highlight the importance of staying up-to-date with the latest developments in order to provide cutting-edge healthcare services.
"Our Team Of Digital Artisans Is Passionate About Pushing The Boundaries Of What's Possible In The Digital Realm. Let Us Be The Architects Of Your Success – Where Creativity Knows No Limits."
Bayard Herbert Swope
Emerging Trends in Medical Laboratories
Positive impact on public health: Early disease detection contributes to public health initiatives by identifying and addressing outbreaks, implementing preventive measures, and reducing the spread of contagious diseases.
By detecting diseases in their early stages, medical laboratories contribute to better treatment outcomes, improved quality of life, and overall healthcare effectiveness.

Must explain to you how all this mistaken idea of denouncing pleasure and praising pain was born and I will give you a complete account of the system, and expound the actual teachings of the great explorer of the truth, the master-builder of human happiness. No one rejects, dislikes, or avoids pleasure itself.
3 Reply on “ The Role of Medical Laboratories in Infectious Disease Testing”
-
Sophie Rain
10 March, 2025Our business consulting programs helps to break the performance of your business down into customers and product groups so you know exactly which customers.
-
Jordi Carlo
10 March, 2025Our business consulting programs helps to break the performance of your business down into customers and product groups so you know exactly which customers.
-
kendra Luss
10 March, 2025Our business consulting programs helps to break the performance of your business down into customers and product groups so you know exactly which customers.

Leave a Reply